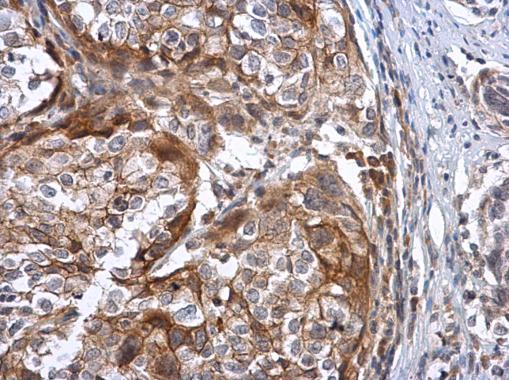
产品封面图

相关产品推荐更多 >
万千商家帮你免费找货
0 人在求购买到急需产品
- 详细信息
- 文献和实验
- 技术资料
- 免疫原:
Recombinant protein encompassing a sequence within the center region of human Sodium/Potassium ATPase beta 3. The exact sequence is proprietary.
- 亚型:
IgG
- 形态:
Liquid
- 保存条件:
Store as concentrated solution. Centrifuge briefly prior to opening vial. For short-term storage (1-2 weeks), store at 4ºC. For long-term storage, aliquot and store at -20ºC or below. Avoid multiple freeze-thaw cycles.
- 克隆性:
Polyclonal
- 标记物:
Unconjugated
- 适应物种:
Human
- 保质期:
12 months from the shipping date of the product.
- 抗原来源:
Human
- 目录编号:
GTX114272
- 级别:
Primary Antibodies
- 库存:
Available
- 供应商:
GeneTex
- 宿主:
Rabbit
- 应用范围:
WB, IHC-P, IHC
- 浓度:
0.26 mg/ml (Please refer to the vial label for the specific concentration.)
- 靶点:
Sodium/Potassium ATPase beta 3
- 抗体英文名:
Sodium/Potassium ATPase beta 3 antibody [N2C3]
- 抗体名:
Sodium/Potassium ATPase beta 3 抗体 [N2C3]
- 规格:
100 μl/25 μl
| 规格: | 100 μl | 产品价格: | ¥4000.0 |
|---|---|---|---|
| 规格: | 25 μl | 产品价格: | ¥1700.0 |
ATPase beta3 (Na+/K+) antibody [N2C3] detects ATPase beta3 (Na+/K+) protein at cytoplasm in human cervical carcinoma by immunohistochemical analysis.
Sample: Paraffin-embedded human cervical carcinoma.
ATPase beta3 (Na+/K+) antibody [N2C3] (GTX114272) diluted at 1:500.
Antigen Retrieval: Citrate buffer, pH 6.0, 15 min
Sample (30 ug of whole cell lysate)
A: Hela
12% SDS PAGE
ATPase beta3(Na+/K+) antibody
GTX114272 diluted at 1:1000
风险提示:丁香通仅作为第三方平台,为商家信息发布提供平台空间。用户咨询产品时请注意保护个人信息及财产安全,合理判断,谨慎选购商品,商家和用户对交易行为负责。对于医疗器械类产品,请先查证核实企业经营资质和医疗器械产品注册证情况。
文献和实验Wang S et al., Exp Ther Med 2017 (Epub)
Wang Y et al., Analyst 2016 (PMID:27140873)
Boral D et al., Cancers (Basel) 2020 (PMID:32575420)
Wang S et al., Exp Ther Med 2017 (PMID:28810580)
,后来发现与我买的beta-catenin一抗(中杉金桥分装的santa cruz的产品)说明书上的结果一致。请问大家做beta-catenin免疫荧光用的是哪里的抗体啊,或者是我的方法有问题吗?我也用0.5%TritonX-100打孔了,仍不行。我在这里先谢谢各位了! zhao22840718 还有一种方法不知有没有人试过,就是把beta-catenin构建到pEGFP-N3类载体中,表达融合蛋白,把载体转入细胞,然后加入你的药物。荧光显微镜下观察进核情况
Beta-gal staining of eukaryotic cells in vitro
off glutaraldehyde 5. Wash 2 x 2 ml PBS. Aspirate 6. Stain for b-gal with X-gal soln. 7. Incubate 37�, 5% CO2 2h - o/n
secondary antibody review -- data from 99 publications
cytometry used as a control to detect cell responses targeted antigen 7 Alexa Fluor 488 7 Cy3 8 goat IgG Alexa Fluor 488 1:2000 detect antibody binding in human embryonic kidney 293T cells Invitrogen 9 donkey
技术资料暂无技术资料 索取技术资料

![Integrin beta 3 antibody [ITGB3/1713]](https://img1.dxycdn.com/2022/0328/893/3826264014011700453-14.jpg!wh200)
![CD99 antibody [MIC2/1495R]](https://img1.dxycdn.com/2022/0328/472/7376804382810700453-14.jpg!wh200)

![VEGFA antibody [MAB0705]](https://img1.dxycdn.com/2022/0328/597/3889682063899400453-14.jpg!wh200)
![Survivin antibody [2D9]](https://img1.dxycdn.com/2022/0328/197/0011965504188500453-14.jpg!wh200)
